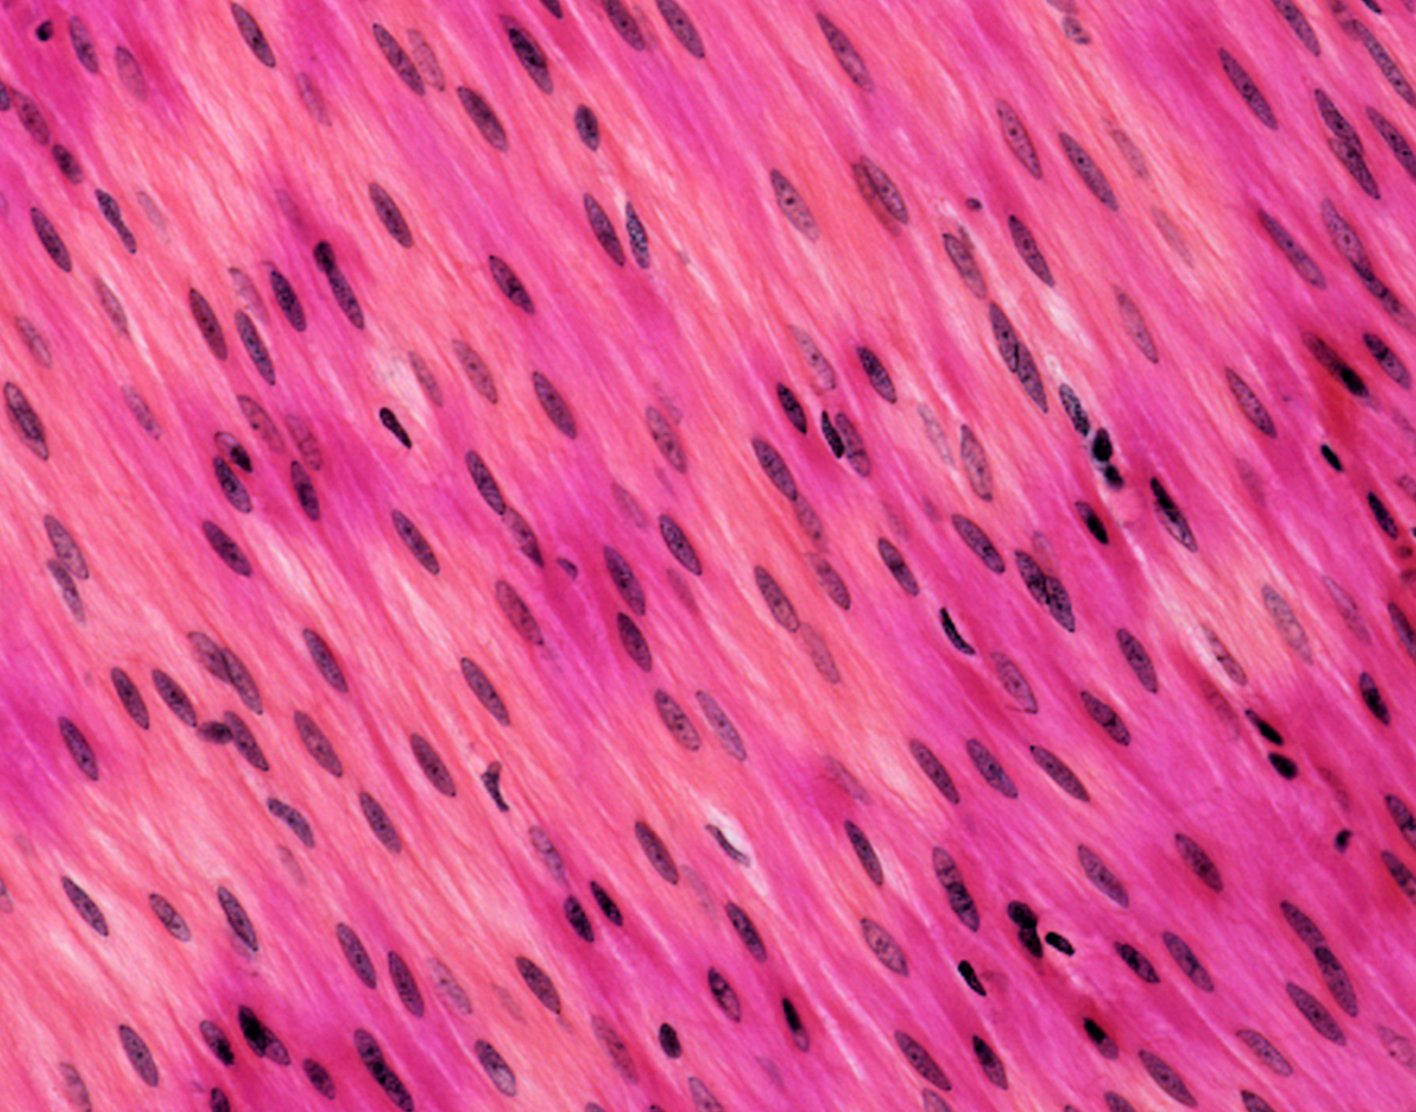

Anti-smooth muscle antibody
Definition
Anti-smooth muscle antibody is a blood test that detects the presence of
How the Test is Performed
A blood sample is needed. This may be taken through a vein. The procedure is called a
How to Prepare for the Test
No special steps are needed to prepare for this test.
How the Test will Feel
When the needle is inserted to draw blood, some people feel moderate pain. Others may feel only a prick or stinging sensation. Afterward, there may be some throbbing.
Why the Test is Performed
You may need this test if you have signs of certain liver diseases, such as
Anti-smooth muscle antibodies are not often seen in diseases other than autoimmune hepatitis. Therefore, it is helpful to make the diagnosis. Autoimmune hepatitis is treated with immunosuppressive medicines. People with autoimmune hepatitis often have other autoantibodies. These include:
- Antinuclear antibodies.
- Anti-actin antibodies.
- Anti-soluble liver antigen/liver pancreas (anti-SLA/LP) antibodies.
- Other antibodies may be present, even when the anti-smooth muscle antibodies are absent.
The diagnosis and management of autoimmune hepatitis may require a liver biopsy.
Normal Results
Normally, there are no antibodies present.
Note: Normal value ranges may vary slightly among different laboratories. Talk to your health care provider about the meaning of your specific test results.
What Abnormal Results Mean
A positive test may be due to:
- Chronic active autoimmune hepatitis
- Cirrhosis
Infectious mononucleosis
The test also helps distinguish
Risks
Risks associated with having blood drawn are slight, but may include:
- Excessive bleeding
- Fainting or feeling lightheaded
- Hematoma (blood accumulating under the skin)
- Infection (a slight risk any time the skin is broken)
References
Czaja AJ. Autoimmune hepatitis. In: Feldman M, Friedman LS, Brandt LJ, eds. Sleisenger and Fordtran's Gastrointestinal and Liver Disease. 11th ed. Philadelphia, PA: Elsevier; 2021:chap 90.
Ferri FF. Laboratory values and interpretation of results. In: Ferri FF, ed. Ferri's Best Test: A Practical Guide to Clinical Laboratory Medicine and Diagnostic Imaging. 5th ed. Philadelphia, PA: Elsevier; 2023:139-252.
Tanaka A. Autoimmune Hepatitis: 2019 Update. Gut Liver. 2020;14(4):430-438. doi: 10.5009/gnl19261. PMID: 32301319; PMCID: PMC7366136.
Williams MJ, Gordon-Walker TT. Hepatology. In: Penman ID, Ralston SH, Strachan MWJ, Hobson RP, eds. Davidson's Principles and Practice of Medicine. 24th ed. Philadelphia, PA: Elsevier; 2023:chap 24.
Review Date: 25/01/2023
The information provided herein should not be used during any medical emergency or for the diagnosis or treatment of any medical condition. A licensed physician should be consulted for diagnosis and treatment of any and all medical conditions. Call 911 for all medical emergencies. Links to other sites are provided for information only -- they do not constitute endorsements of those other sites. Copyright ©2019 A.D.A.M., Inc., as modified by University of California San Francisco. Any duplication or distribution of the information contained herein is strictly prohibited.
Information developed by A.D.A.M., Inc. regarding tests and test results may not directly correspond with information provided by UCSF Health. Please discuss with your doctor any questions or concerns you may have.